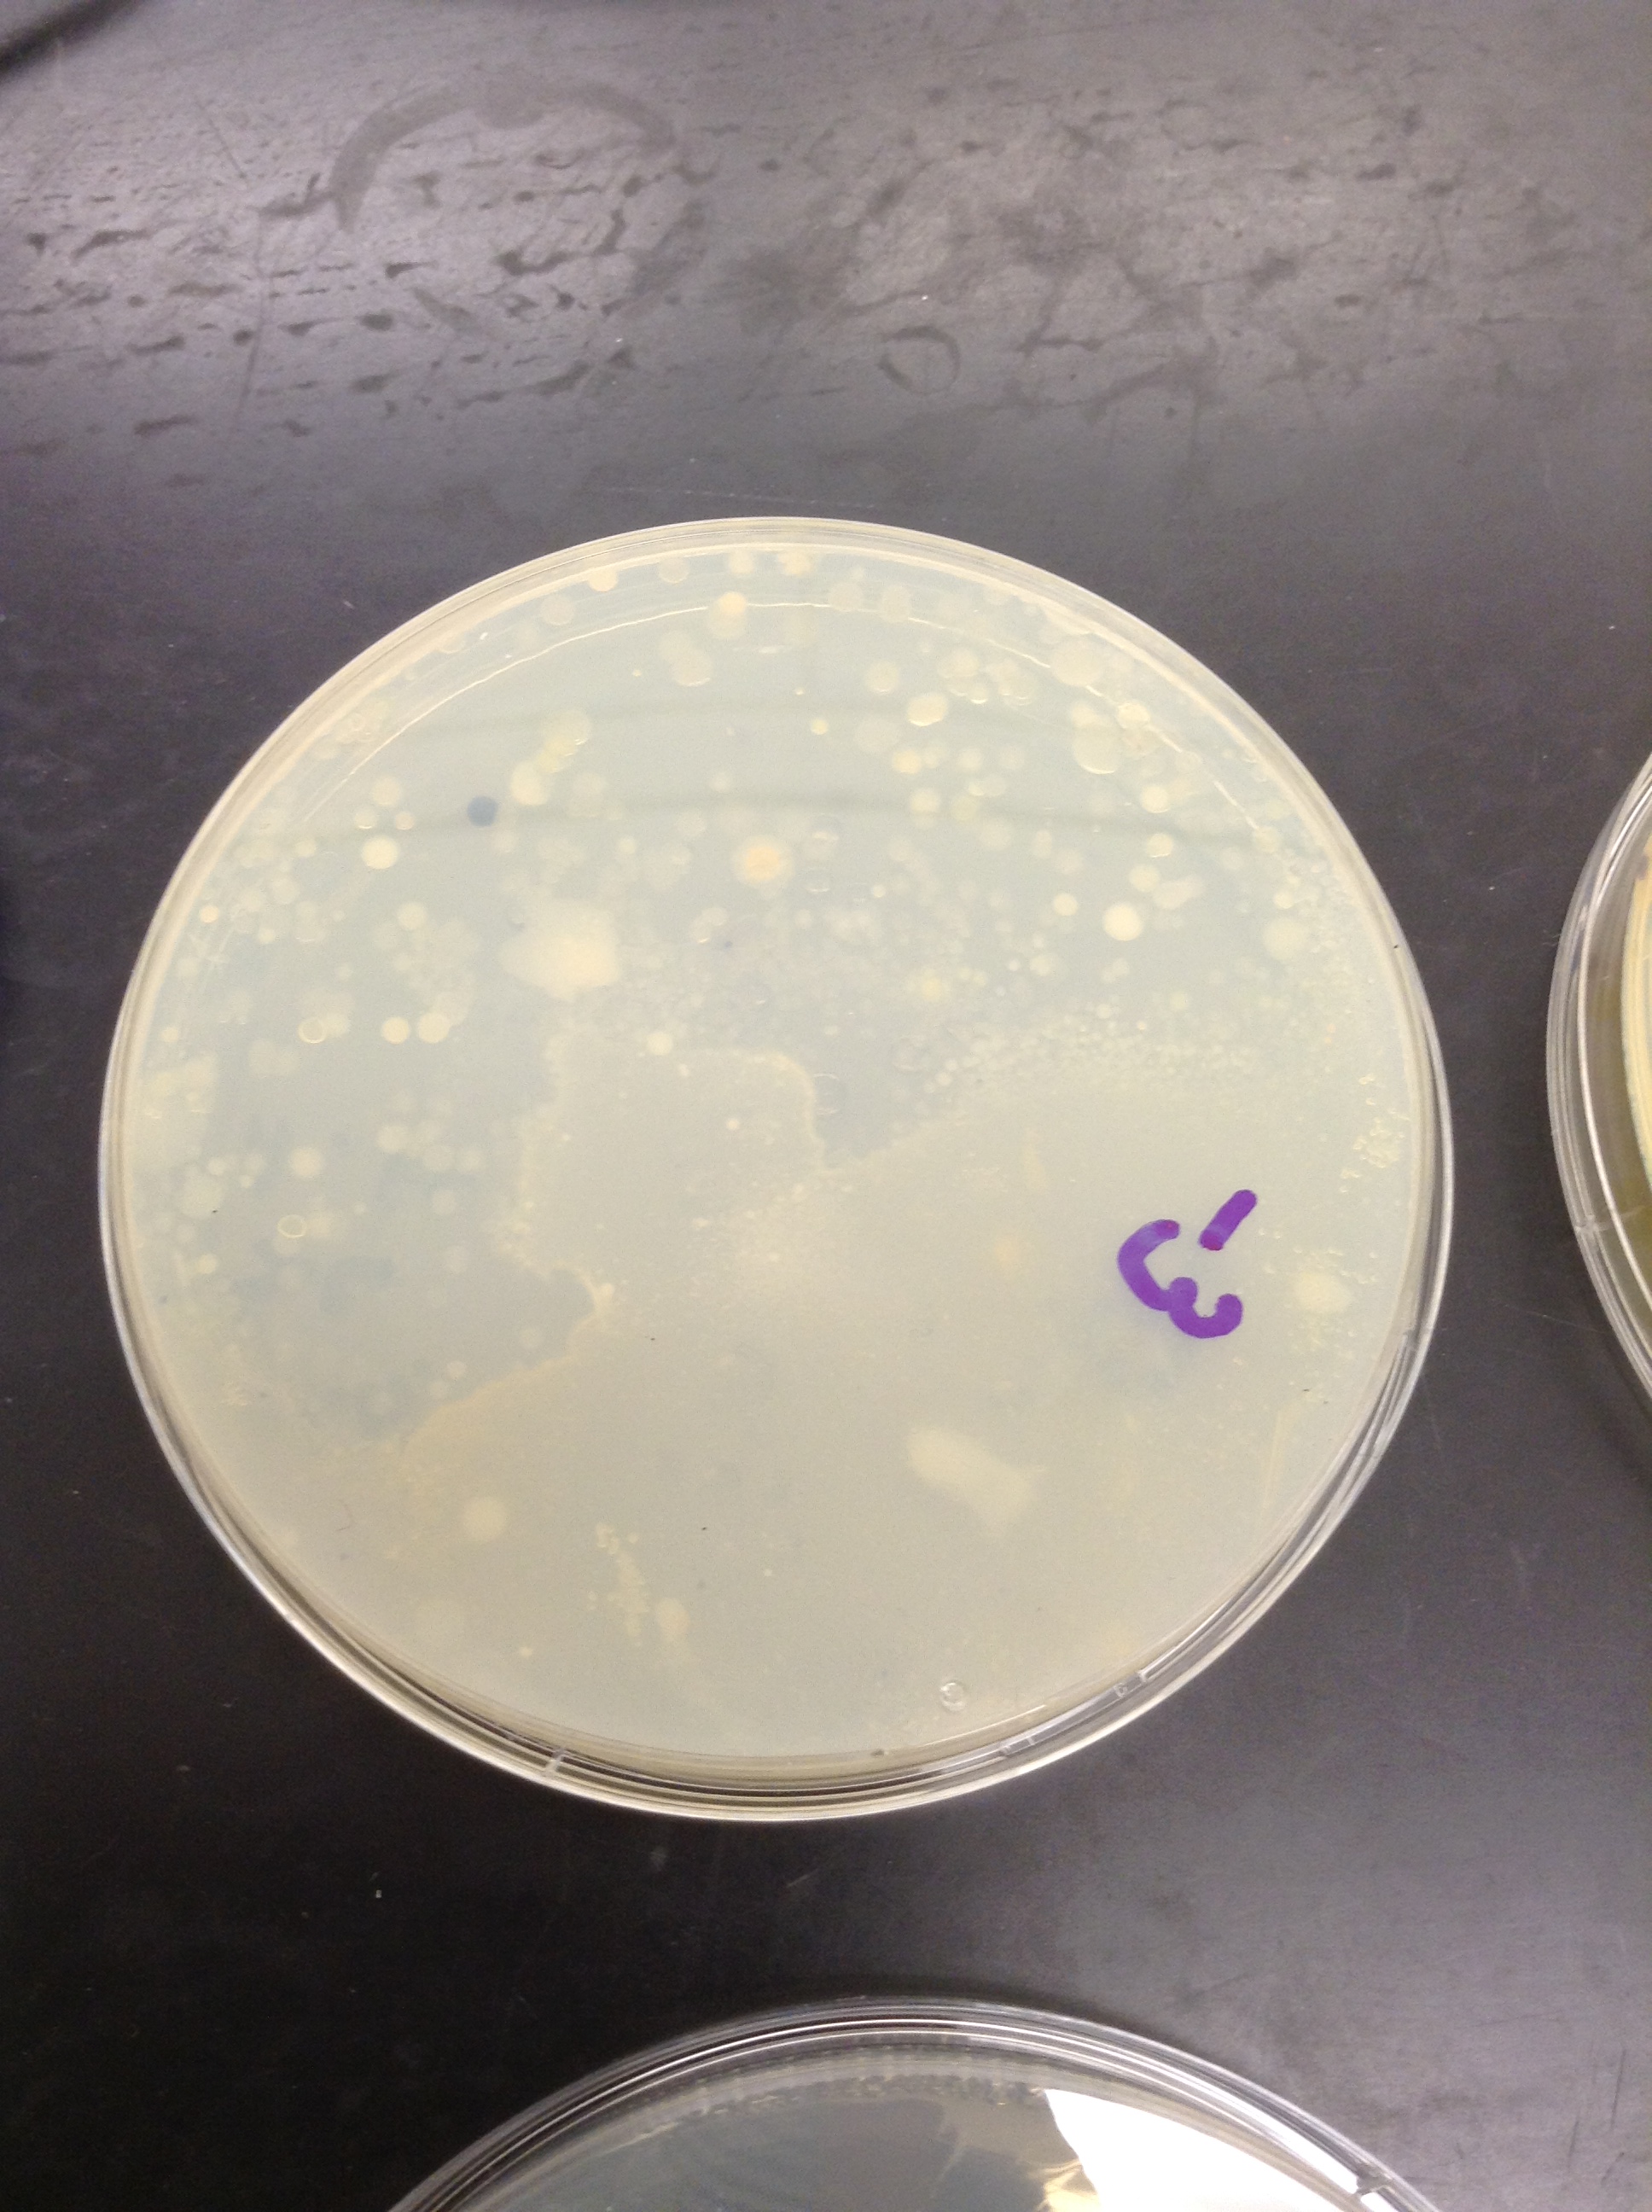
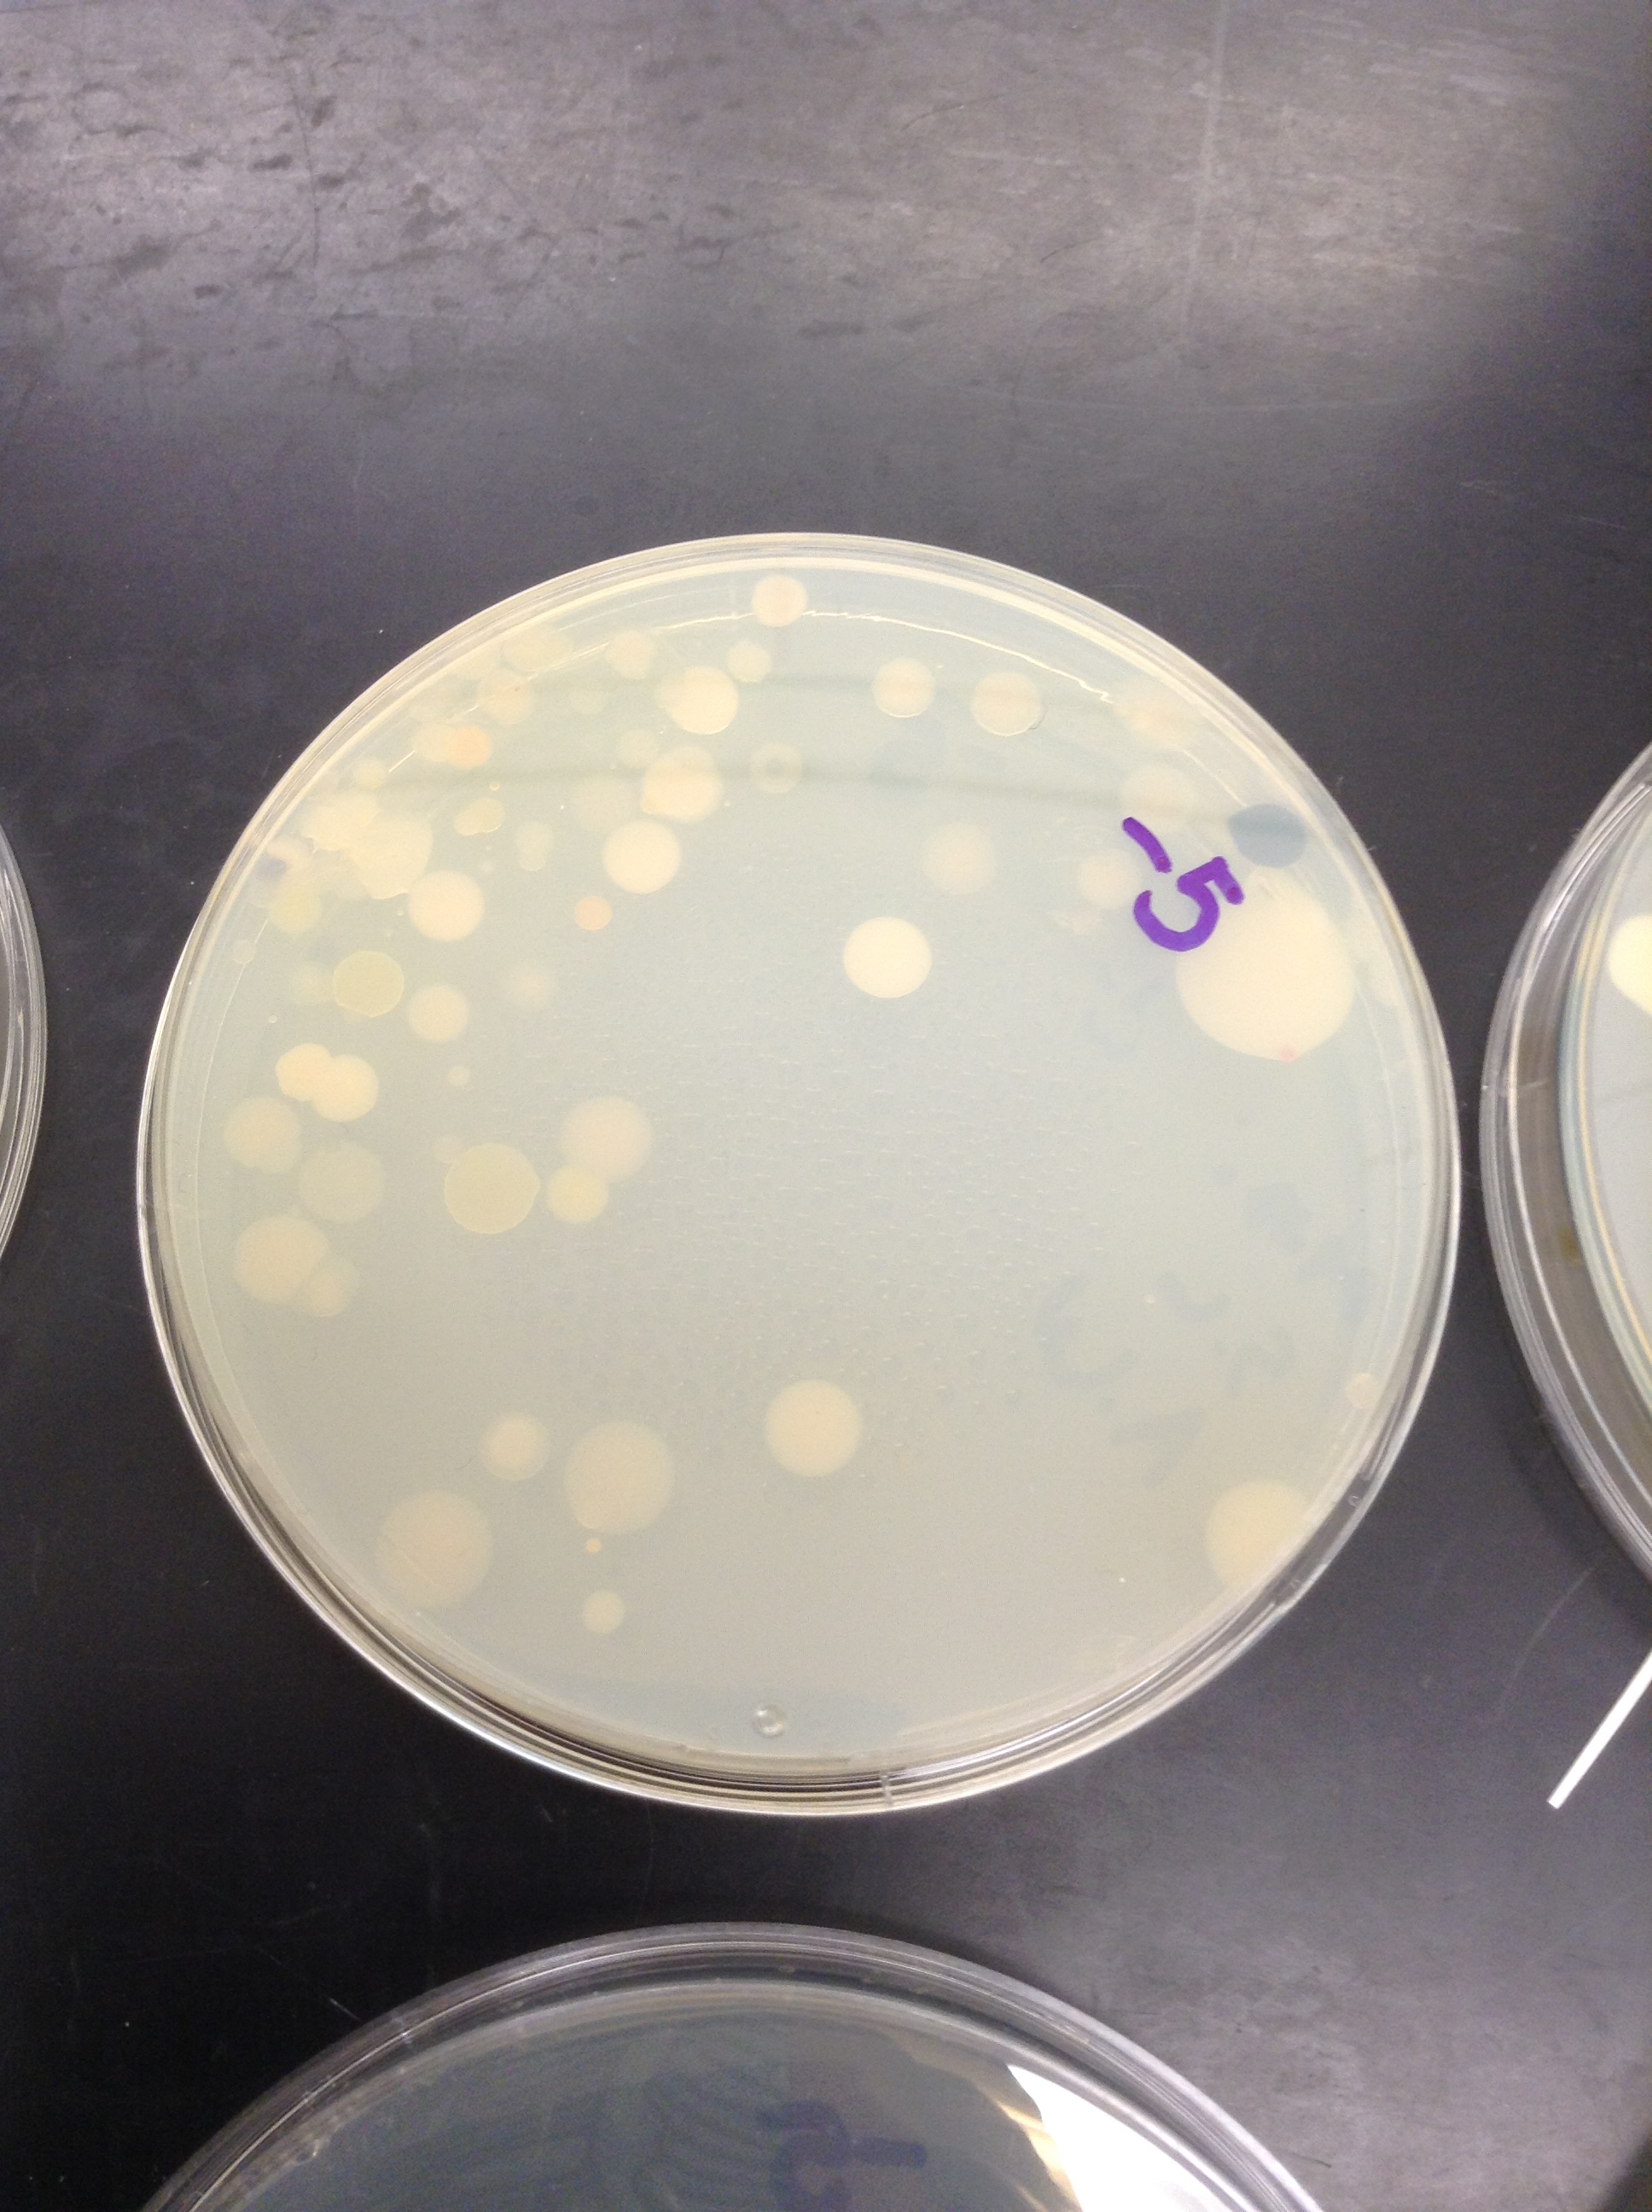
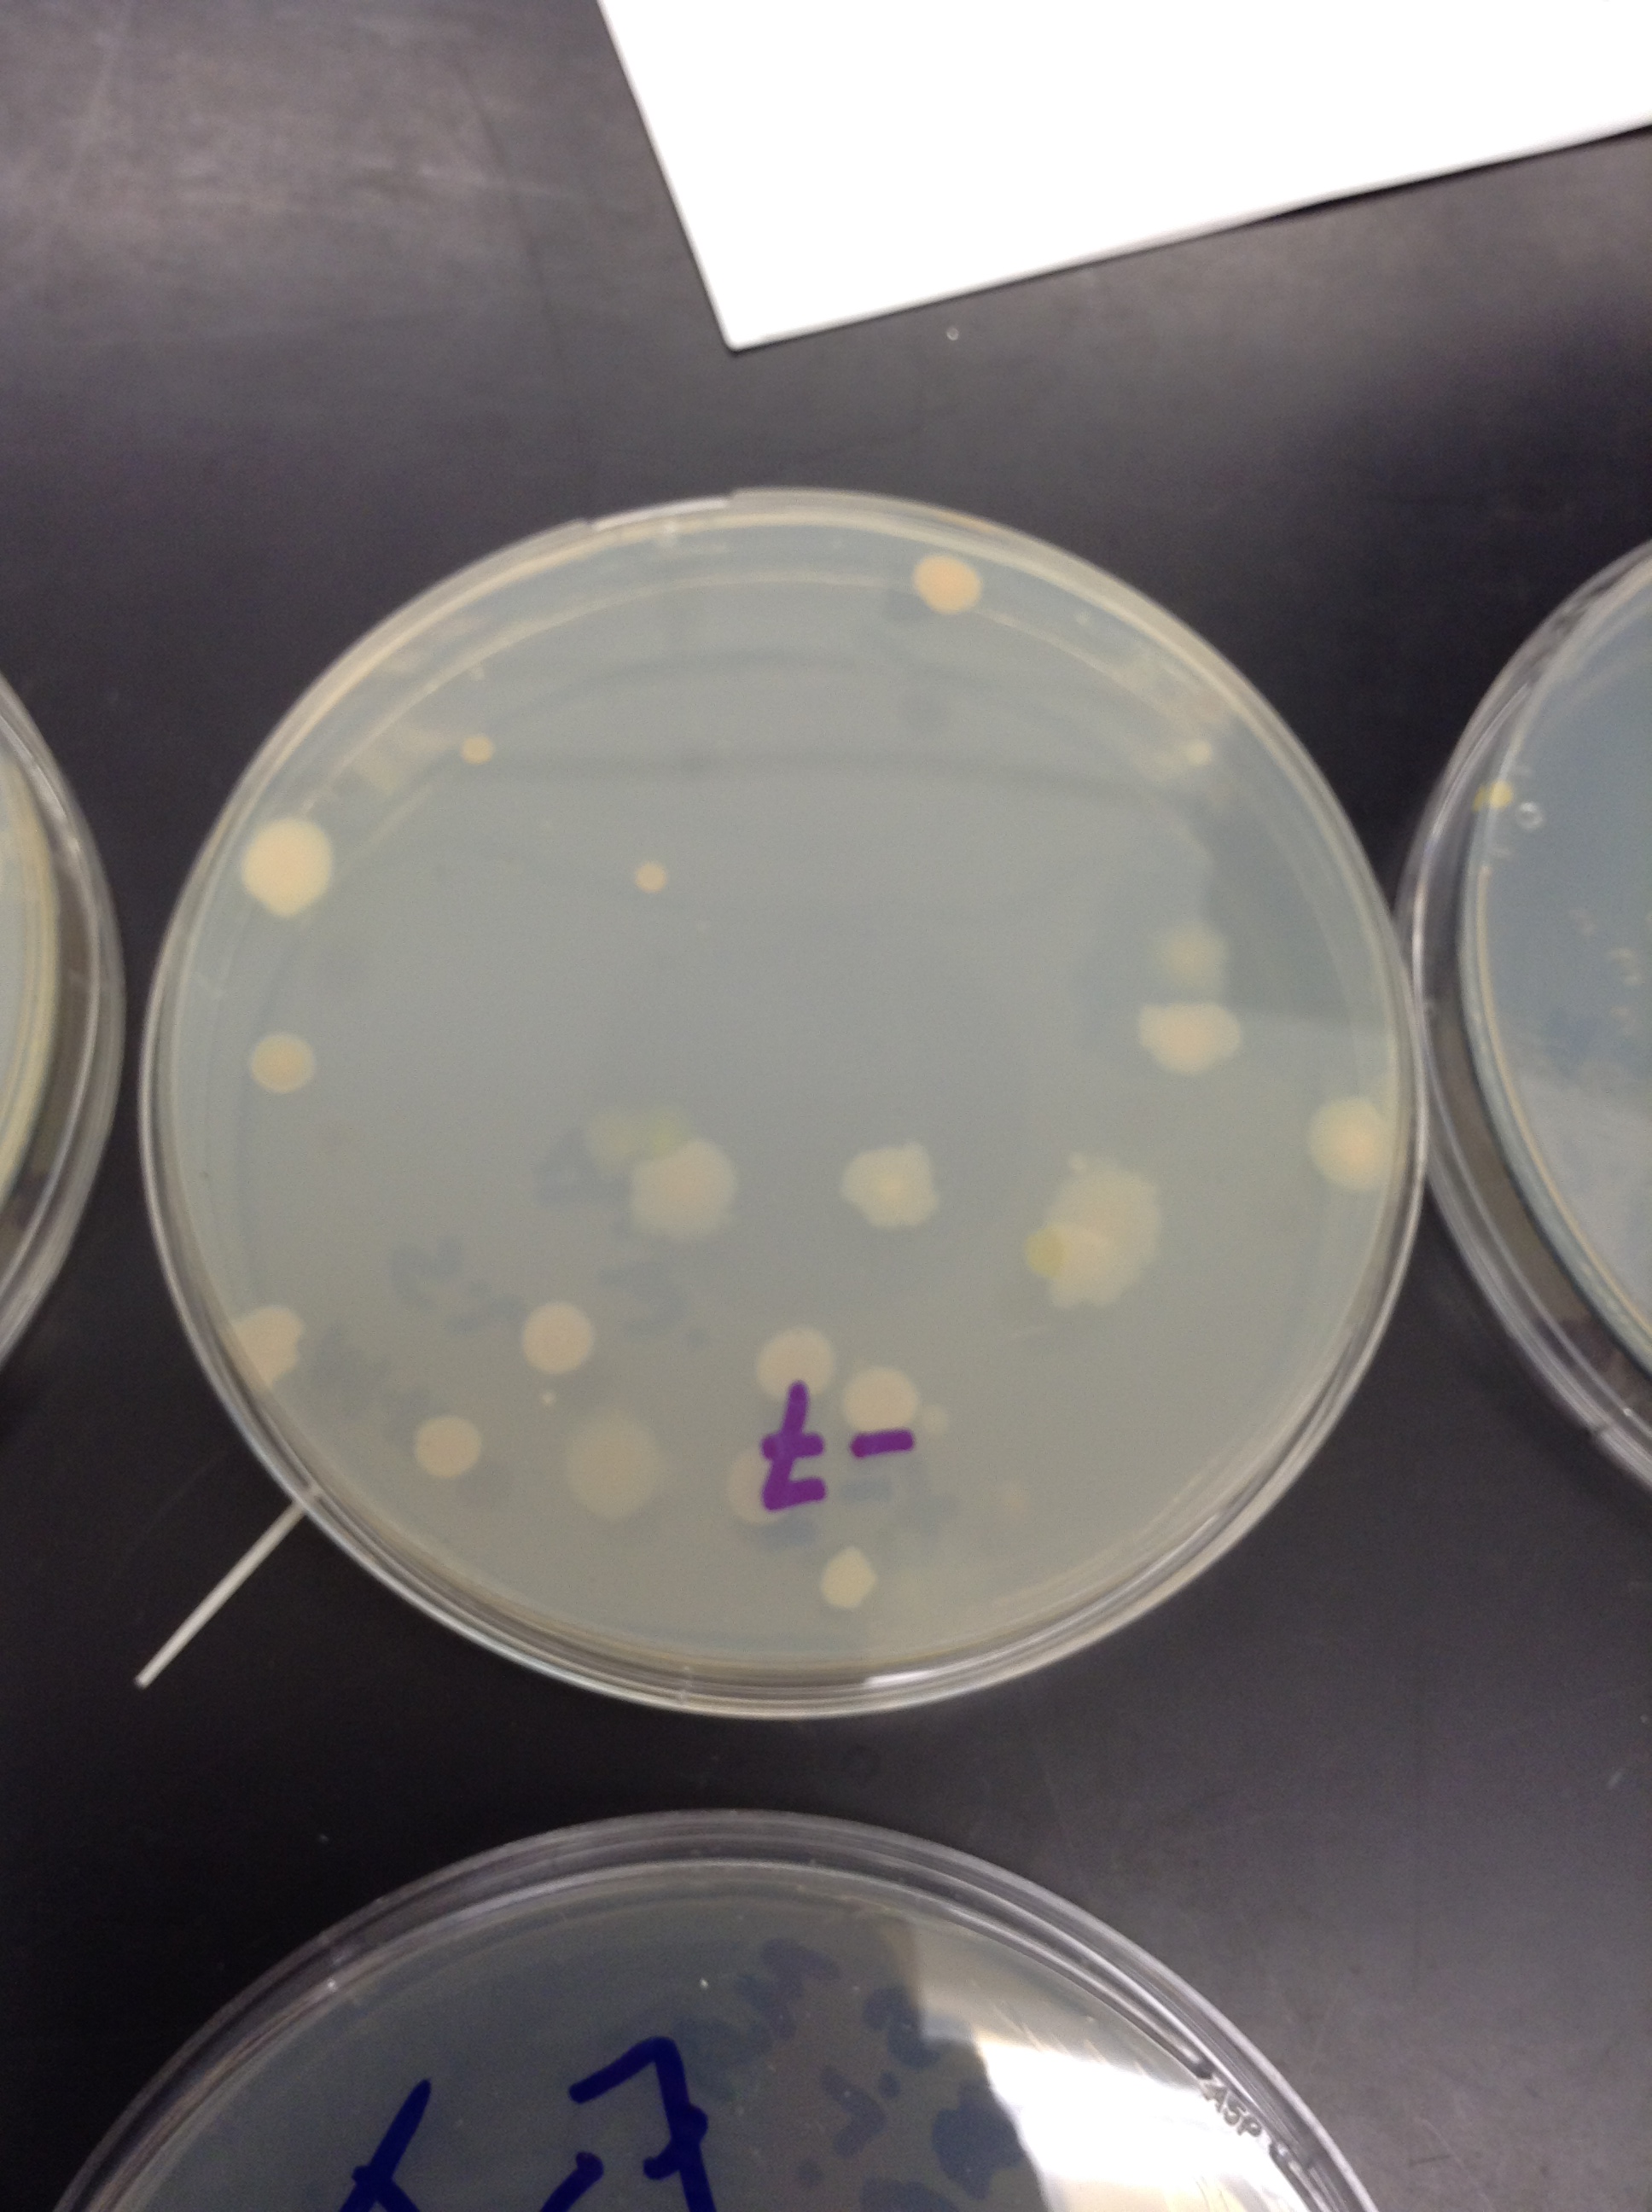
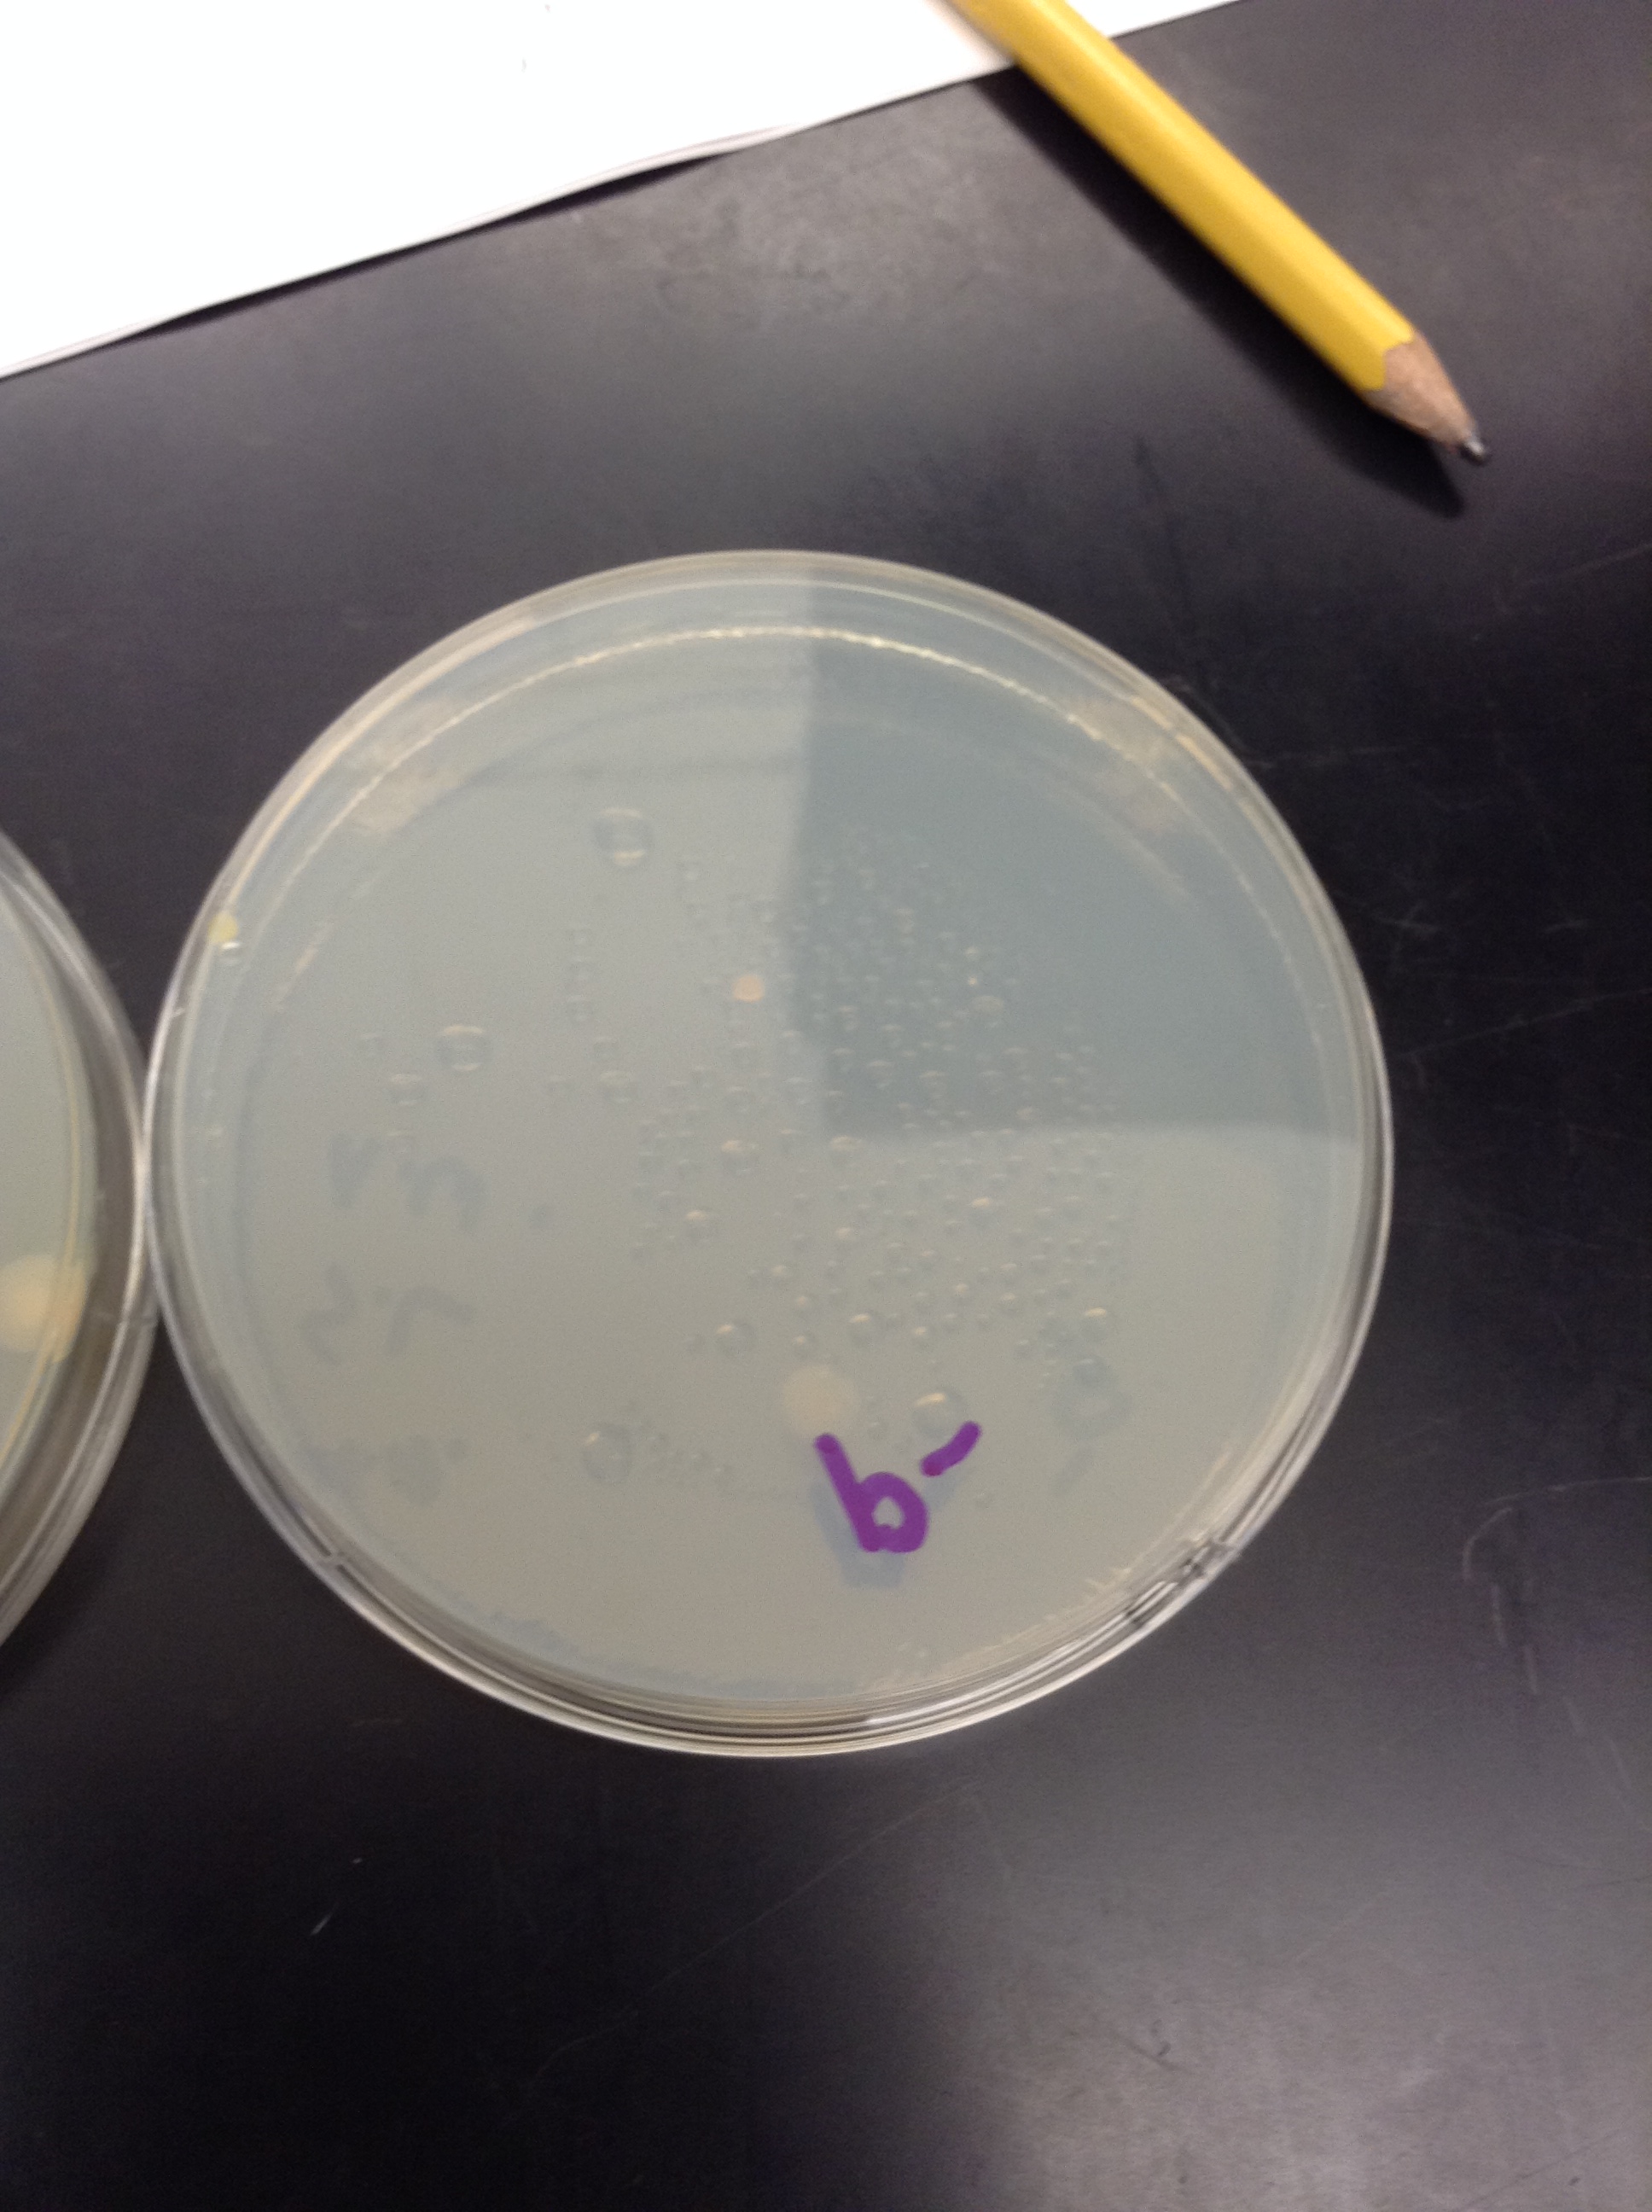
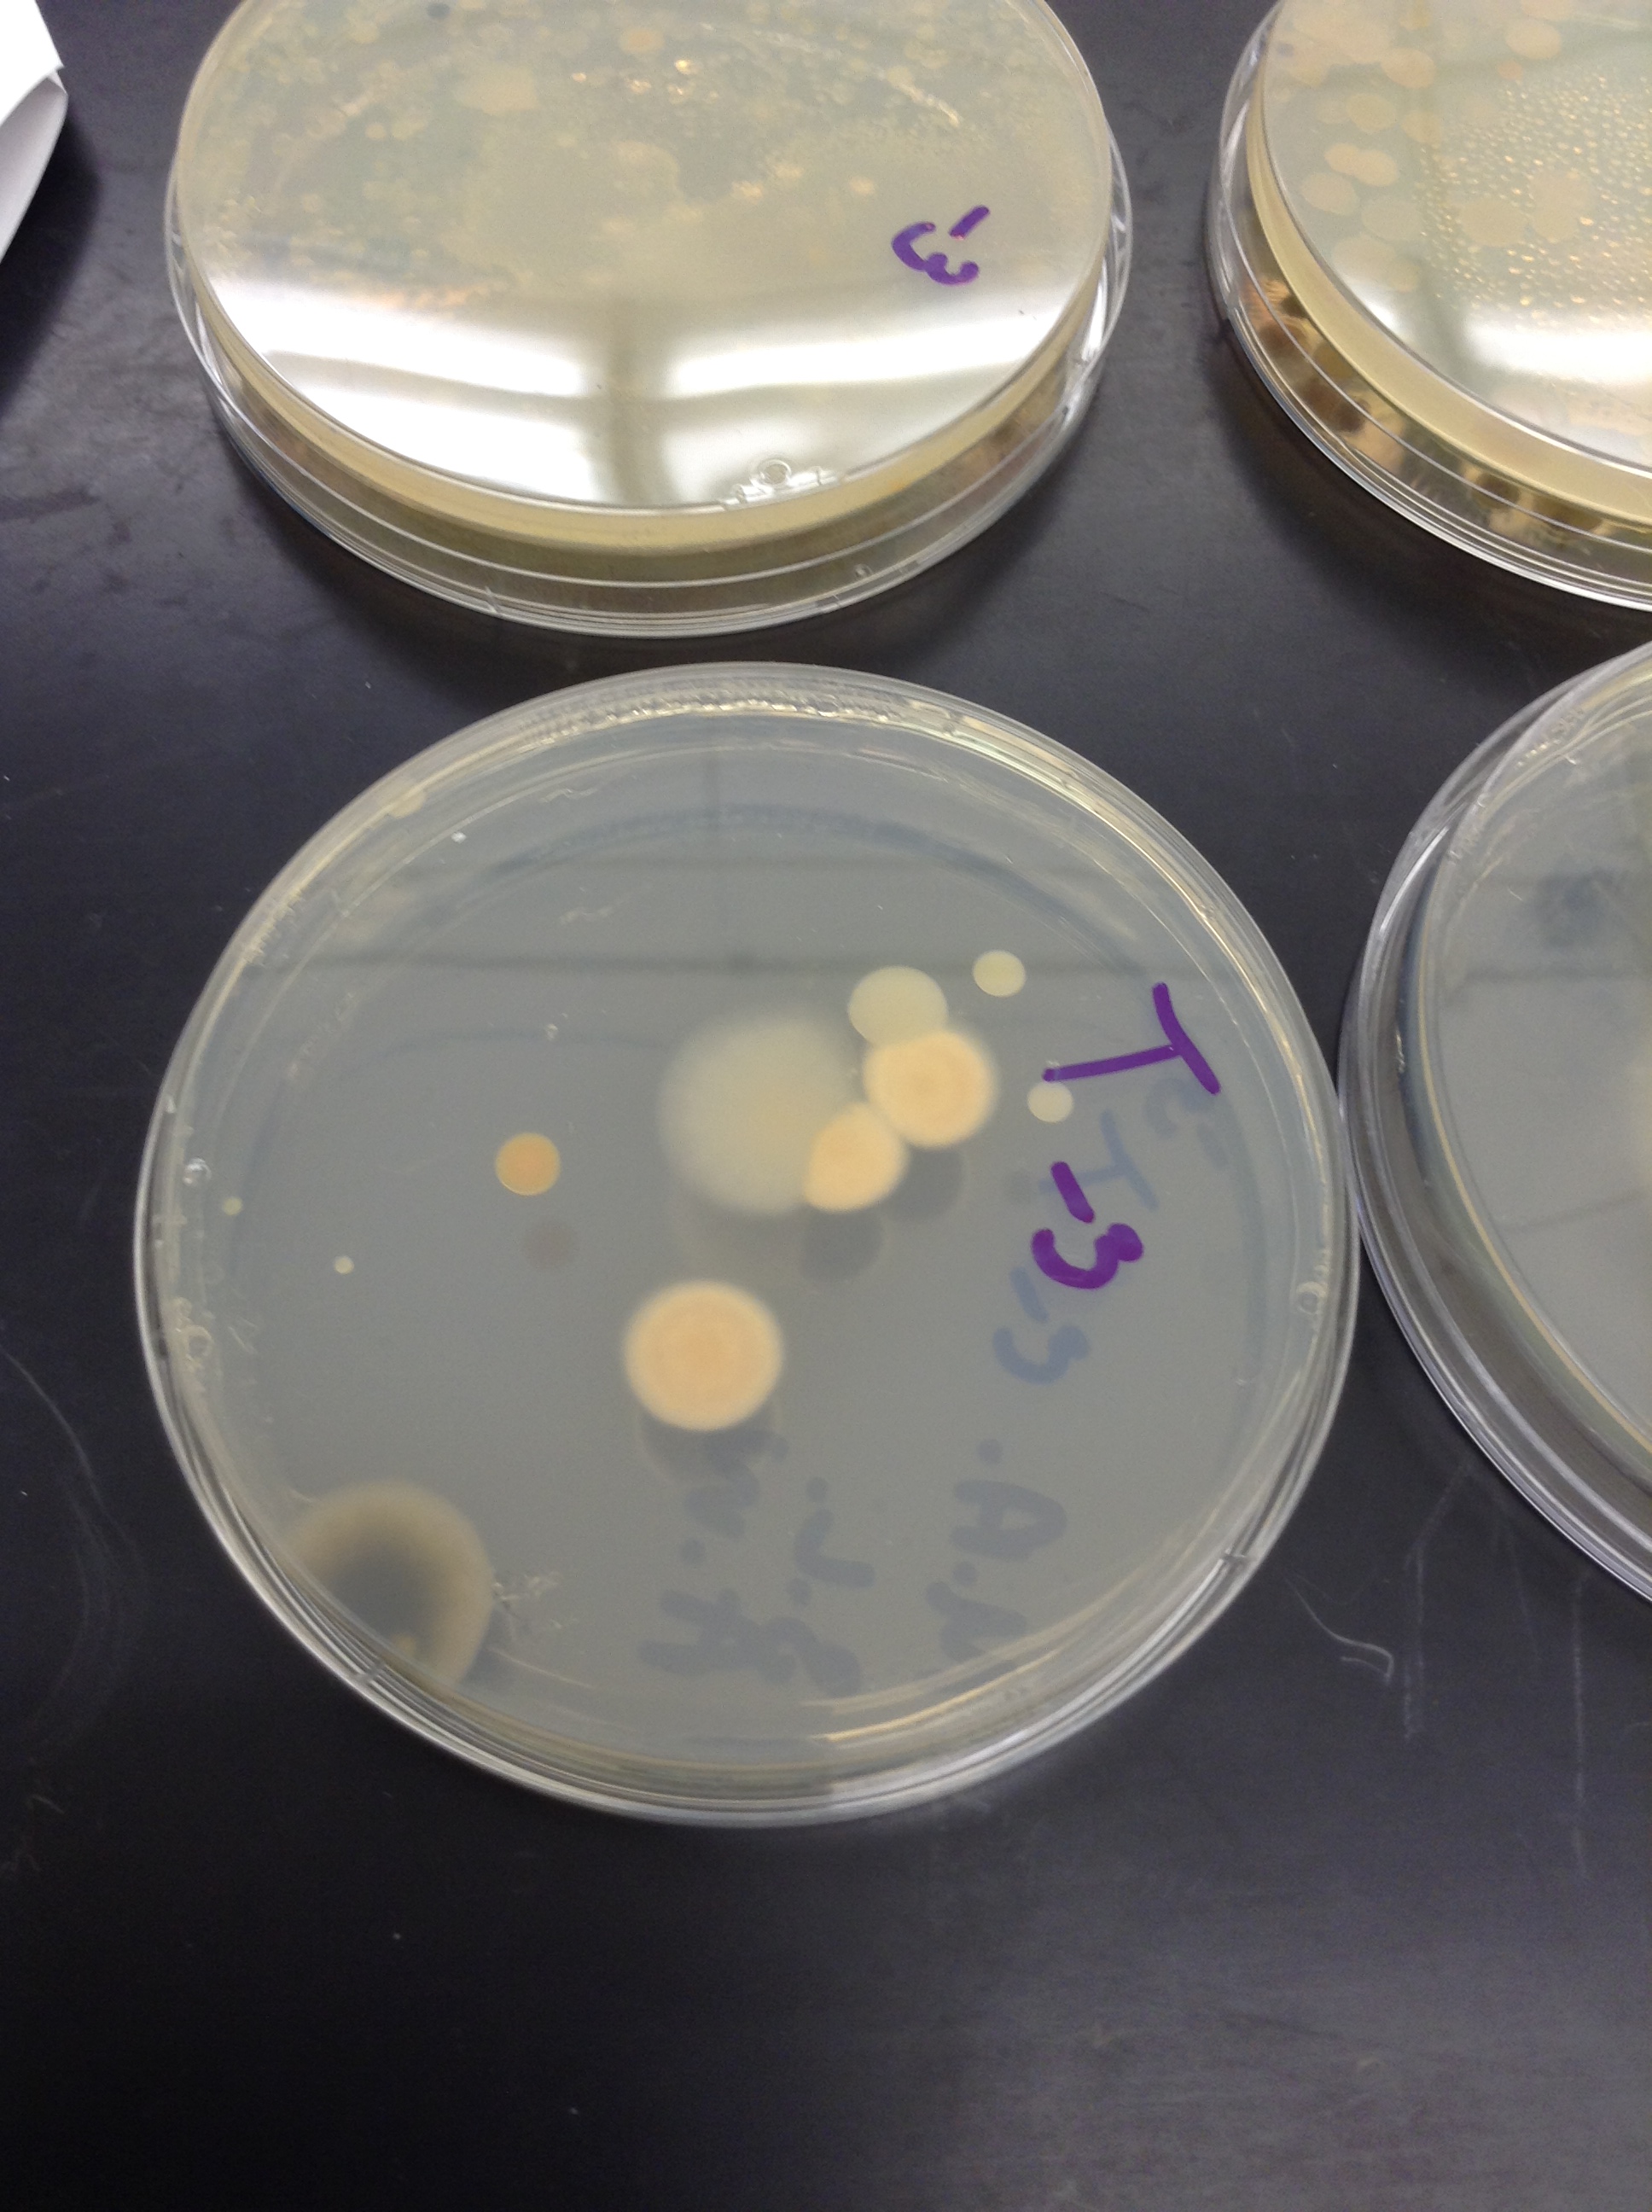
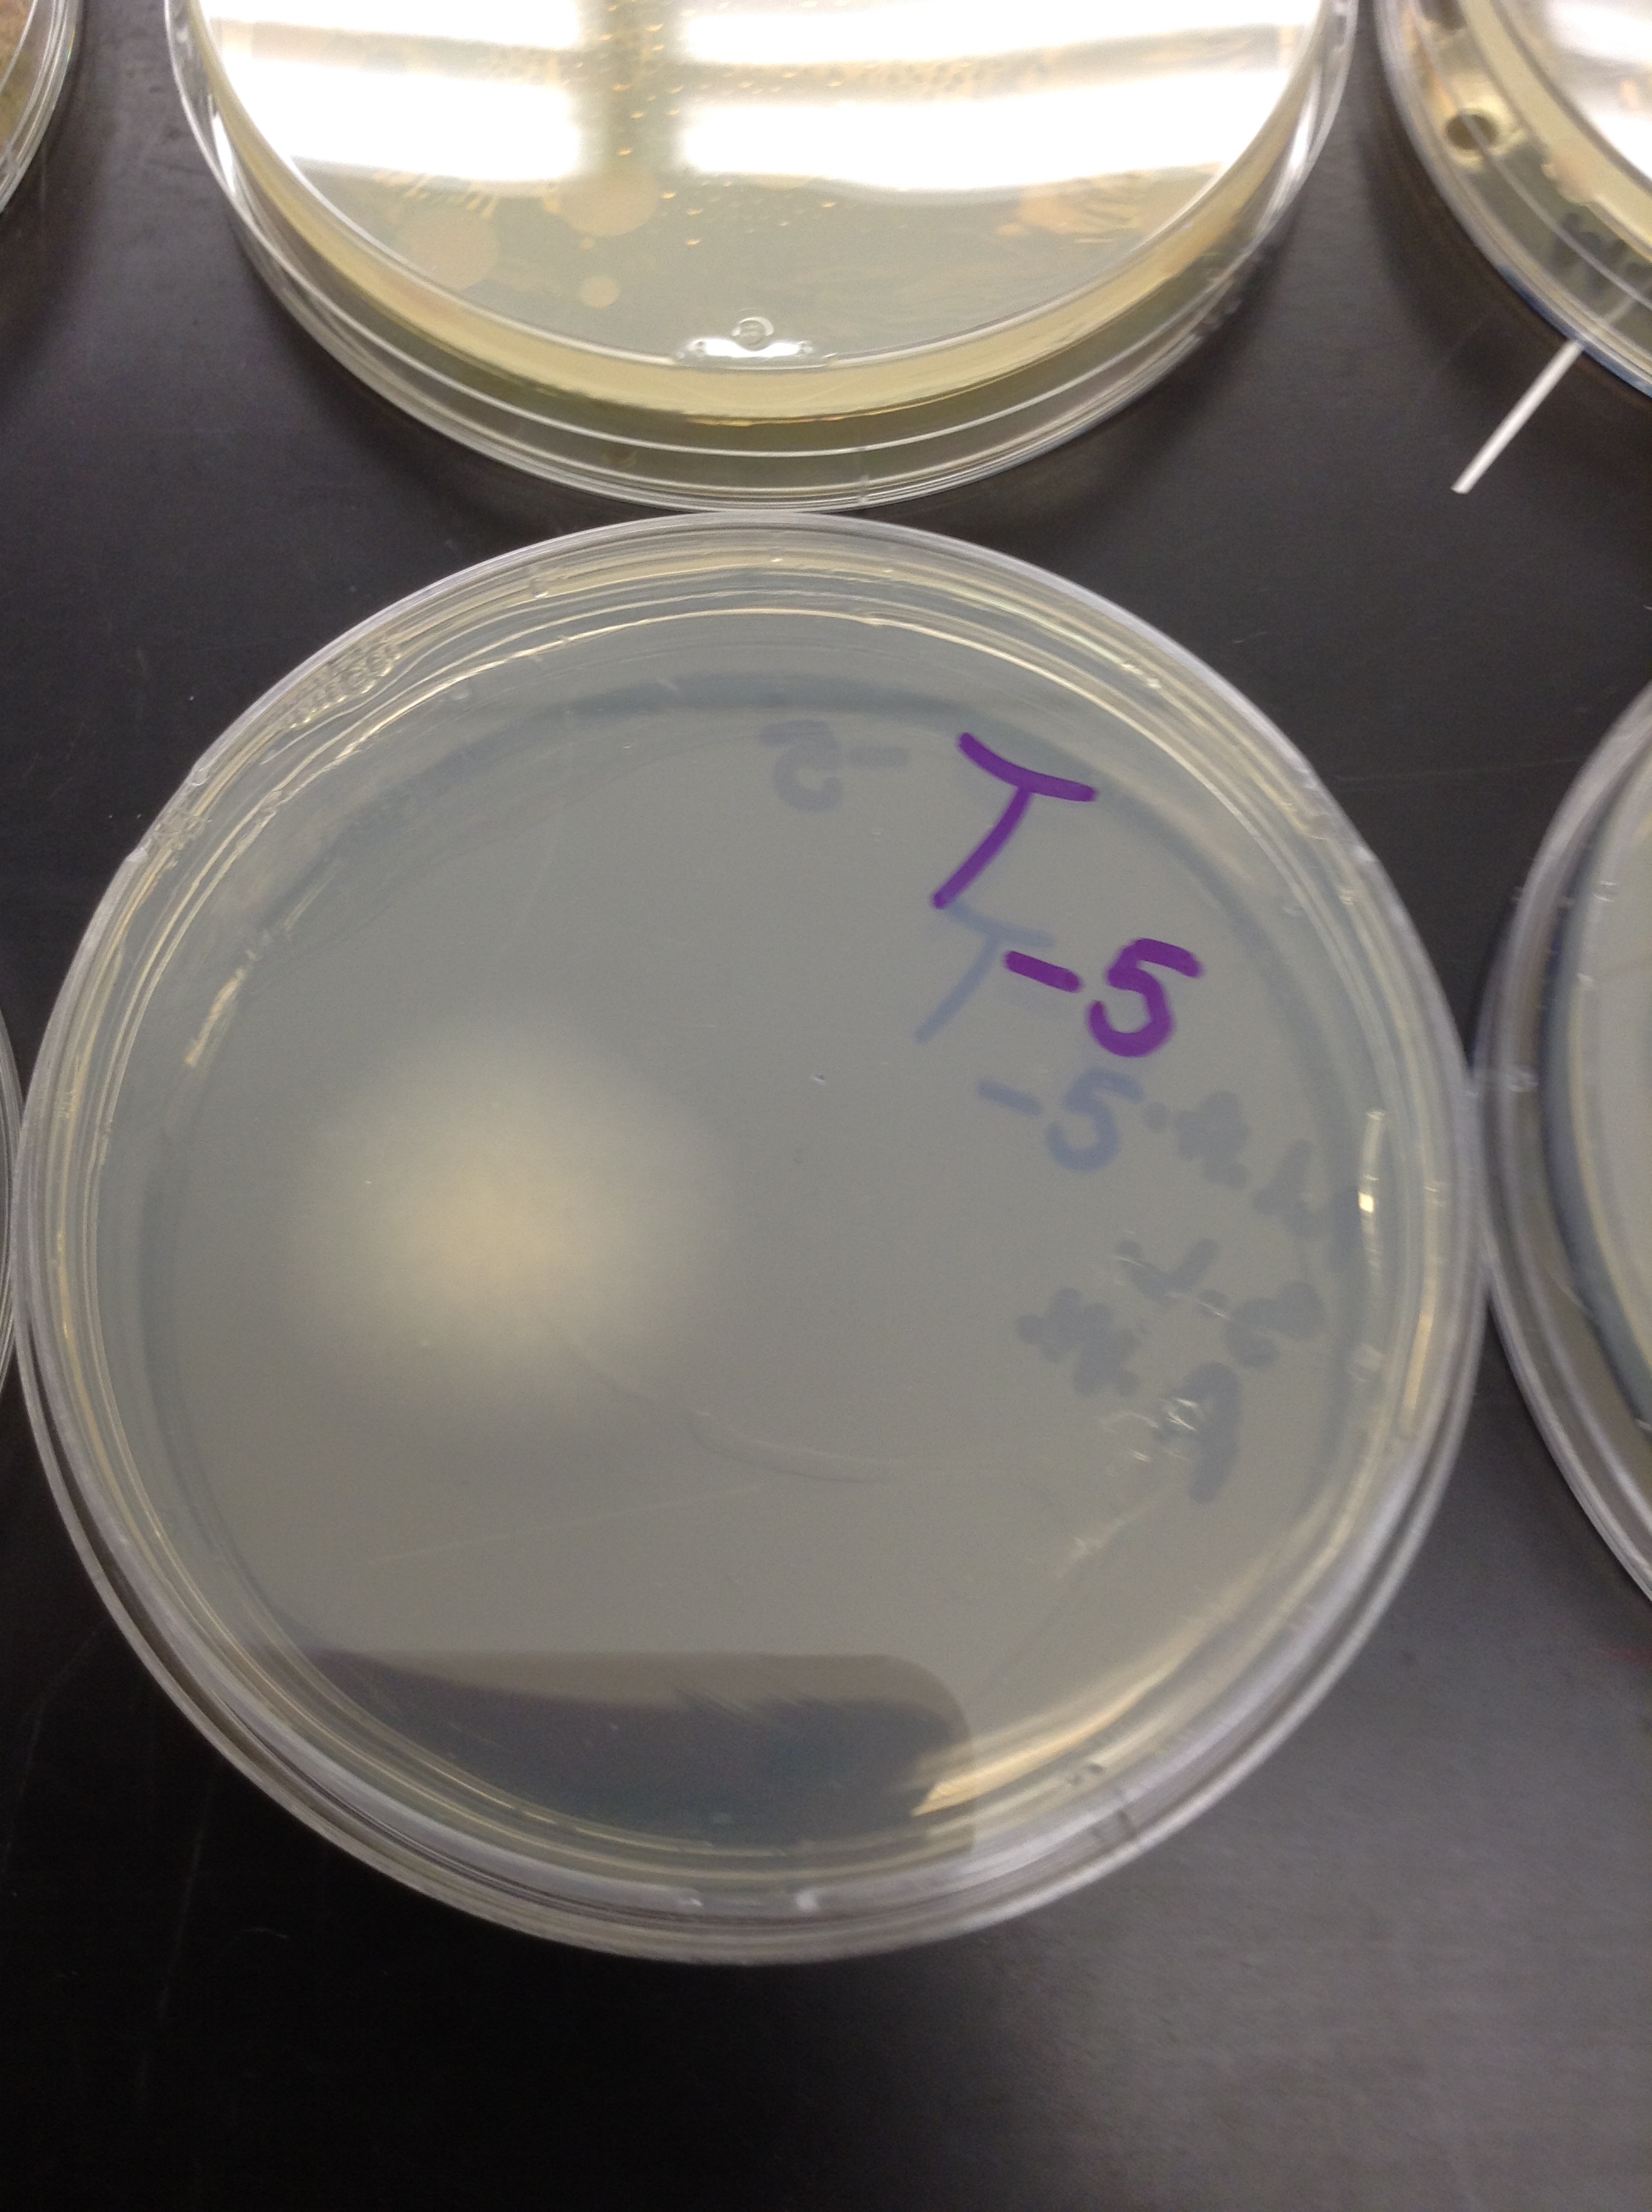
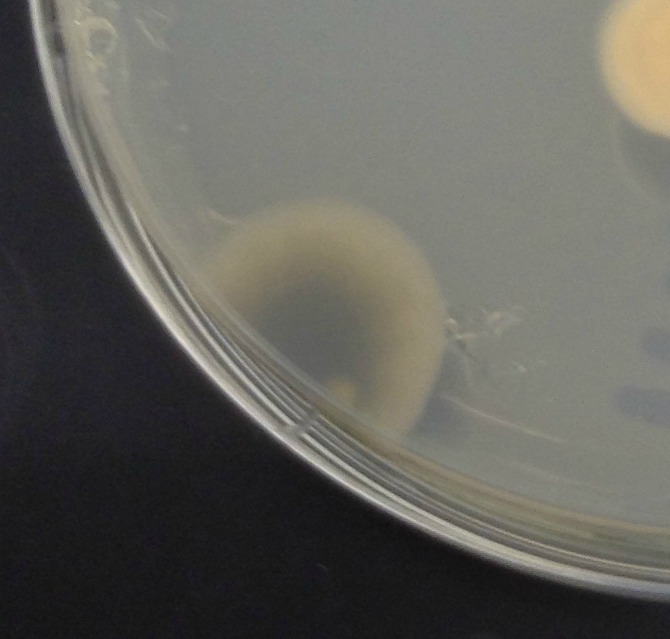

User:Makuo C. Aneke/Notebook/Biology 210 at AU
Lab 3 Addition: 4/24/2014
NCBI Blast This is an update on gene analysis as a part of Lab 3. Our first sequence codes for Chryseobacterium indologenes, the second codes for Pseudomonas cedrina, and the third codes for Methylobacterium rhodinum. ...
Lab 4: 4/23/2014
Objective
In lab 6, we study the differences in embryonic development in various organisms.

Hypothesis If zebrafish embryos show the same symptoms as human fetuses when exposed to alcohol, then they will be good examples for studying Fetal Alcohol Syndrome in humans.
Procedure Two groups of 20 zebrafish per group were placed in petri dishes. The first group of zebrafish was made the control group and we placed them in 20 mLs of Deerpark water. The second was the experimental group and they were placed in 20 mLs of a 1.5% ethanol solution. The zebrafish were then monitered frequently for 2 weeks: Day 4: 10 mLs of water or ethanol were removed along with any empty egg cases; 25 mLs of freshwater or ethanol were added to the petri dishes Day 7: 5 mLs from each dish were removed and replaced with 5 mLs; 3 zebrafish from each group were to be fixed in paraformaldehyde, but unfortunately we failed to perform this step Day 11: 5 mLs were removed and 10 mLs were added Day 14: final observations (no zebrafish lived to 2 weeks)
Data Exerimantal: Day 1 - all living; most eyes and eye sockets developed but not as much as control group; vertebral column shows signs of development; less black flecks than control Day 4 - 15 living, 5 dead; many eggs hatched and swimming; at earliest developmental stage; overall eye diameter is less than control; overall inter-eye distance is greater Day 7 - 1 larvae died; long pec-fin stage; bodies have rounder shape and a green-yellow hue Day 14 - all dead Control: Day 1 - all living; eyes have developed and vertebral column can be seen as well as black flecks Day 4 - 17 living, 3 dead; many eggs hatched and swimming; at earliest developmental stage; eyes and body appear normal Day 7 - no deaths; at pec-fin phase; eyes are normal size with a yellowish hue; bodies seem to be of normal size and structure Day 14 - all dead
Conclusion Although we didn't have fixed zebrafish to observe directly, our results support our hypothesis that zebrafish are good model organisms to study FAS in humans because they show the same symptoms during development. Suggestions for improvement in further experimentation would be to use a larger sample size to gain more accurate results. The importance of this experiment is to educate expecting moms who may underestimate the effects of alcohol on her fetus.
--Makuo C. Aneke 19:12, 23 April 2014 (EDT)MA
Lab 5: 2/23/2014
Objective In this lab, we looked at different types of invertebrates and discussed what their forms of movement say about their body structure. Acoelomates, pseudocoelomates, and coelomates were the types of invertebrates that were observed.
Procedure 1) Observe and record the body structures different types of invertebrates, 2) Determine how their body function relates to their type of movement. 3) Look though transect samples to find possible invertebrates. 4) Determine any vertebrates that may inhabit the transect. 5) Create a possible food web.
Data Acoelomates (Planaria) -moved in a gliding fashion -seemed to wander aimlessly around the edges of the plate -indicates a relatively stern but light body structure
Pseudocoelomates (Nematodes) -slithers like a smake -moves relatively fast -indicates a lighter, simpler and more flexible body structure
Coelomates(Earthworms) -moves by compressing and expanding its body -moves slowly compared to other the invertebrates -indicates a relatively strong and rigid body structure
These were the organisms that were available for observation in the lab. Unfortunately, after looking thoroughly through our samples, we could not find any organisms to describe that came from our transect.
Some vertebrates that may inhabit the transect are:
-Squirrels (Chordata, Mammalia, Rodentia, Sciuridae, Sciurus, Sciurus carolinensis ) --squirrels would benefit from the plants and possibly acorns in the transect; also the soil gives them a place to hide their nuts -Rabbits (Chordata, Mammalia, Lagomorpha, Leporidae, Oryctolagus, Cuniculus) --rabbits would benefit from the plants in the transect for food; the height of the plants may allow for rabbits to hide from predators better -Mice (Chordata, Mammalia, Rodentia, Muridae, Mus, Musculus) --mice can use the soft soil in the transect to possibly burrow under it and hide from predators; the basic color of the transect also allows them to blend in with the surroundings and the plants serve as food -Crows (Chordata, Aves, Passeriformes, Corvidae, Corvus, Corvus brachyrhynchos) --crows can use twigs and larger sticks in the transect to make nests and also use the invertebrates living in the soil as food -Finches (Chordata, Aves, Passeriformes, Passeroidia, Fringillidae, Fringilla coelebs) --like crows, finches can eat invertebrates, such as worms and insects, in the soil and use twigs and other size sticks for nests
Conclusion Since we didn't find any invertebrates in our transect sample, we had to make guesses of what invertebrates may inhabit them. Therefore, the food web may not be as accurate as it should be. In the future, we will collect more dirt samples since that's where more of the invertebrates are.
--Makuo C. Aneke 22:16, 23 February 2014 (EST)MA
Lab 4: 2/19/2014
Objective In this lab, we referred back to our transect to identify different types of plants living there. The major group that our plants were a part of were angiosperms. We were also to observe fungi and determine what type it was in order to better determine the diversity within the transect.
Procedure 1) Classify 5 different plants found in transect. 2) Observe fungi on petri dishes and determine what type it is.
Data
Description of Plants (Table 1): 
Fungi sporangia are little, black, circular structures that some fungi grow upward and outward from and they're important because these sporangia are the site of reproduction.
This fungus appears to be very fuzzy and its color gets darker towards the center. Looking closely, there seems to be a colony of bacteria under it as well. The fungus is relatively large and it seems to be raised in the center. I think this fungus belongs in the Ascomycota group because, by observation, it falls under the category of a powdery mildew or mold. I believe that it is a fungus in the first place because it has many characteristics of fungi including a fuzzy, raised-bump structure with whitish hyphae filaments growing around it, lack of chloroplasts (meaning no photosynthesis), and it seems to be free-living.
Conclusion From observing the different types of flowers and fungi, we could conclude that our transect does contain a diverse group of organisms. In the future, we could also classify possible gymnosperms within the transect instead of just angiosperms.
--Makuo C. Aneke 19:26, 19 February 2014 (EST)MA
Lab 3: 2/19/2014
Objective Our objective was to determine the types of bacteria that inhabit our transect.
In this lab, we closely observed our bacteria on agar petri dishes. As for the hay infusion culture, the volume of the water decreased but the color and odor basically remained the same. As mentioned in the last lab, over time the population of bacteria in the culture will increase to carrying capacity while the volume of water decreases due to evaporation. Therefore, hay infusion becomes more dense, the smell becomes stronger, and competition between organisms increases.
Procedure 1) Study the different agar plates to see how much bacteria was affected by tetracycline.
Data
Agar plates:
~10^-3... ~10^-5...
~10^-5... ~10^-7...
~10^-7... ~10^-9...
~10^-9... ~10^-3(tet)...
~10^-3(tet)... ~10^-5(tet)...
~10^-5(tet)... ~10^-7(tet)...
~10^-7(tet)... 
100-fold Serial Dilution Results: 
There is not much of a difference in colony types between the plates with vs. without the antibiotic. The colors and sizes are generally the same. This indicates that a mutation may have occurred in some colonies of bacteria that allowed them to be resistant to tetracycline. On the plates with the tetracycline, there's a drastic decrease in the number of colonies compared to the plates without tetracycline. Also, circles of fungi tended to grow on the plates with the antibiotic and not on the plates without it. Only about 7 species of bacteria were unaffected by tetracycline.
Tetracycline works by attaching itself to the ribosomal acceptor (A) site, therefore preventing aminoacyl-tRNA to bind to it. Both gram-positive and gram-negative bacteria can be susceptible to tetracycline (Collard).
The three petri dishes we used to observe were 10^-3 with tetracycline, and 10^-5 & 10^-7 without tetracycline.
Conclusion Results support that there is a diverse group of bacteria in our transect because the were some bacteria that were resistant to the tetracycline and able to reproduce. With future observations, we could collect bacteria from deeper withing the soil to see if that moister environment will contain more different types of bacteria, further supporting the fact that even though the transect is small, it has a wide variety of organisms and micro-organisms.
Collard, Jean-Marc. "Tetracycline Resistance." Tetracycline Resistance. Service of Biosafety & Biotechnology, n.d. Web. 19 Feb. 2014. http://www.antibioresistance.be/tetracycline/menu_tet.html
--Makuo C. Aneke 18:44, 19 February 2014 (EST)MA
Lab 2: 2/19/2014
Objective To understand the characteristics of algae and protists and how to use a dichotomous key; this will help us in identifying micro-organisms in our transect.
Procedure 1) To observe the different types of bacteria that grew in our hay infusion cultures The our culture looked like a swamp and had a greenish-brown color. The odor was very unpleasant, similar to rotting food. There was a thin layer of a brown substance on the surface of the culture. 2) To take samples of organisms from two different niches, including one with plant matter. Organisms may differ near vs. away from the plant matter because bacteria living near the plant matter would most likely depend on the nutrients that it provides. 3) Obtain six total samples (three from the top and three bottom of the culture) to observe. 4) Prepare a serial dilution.
Data
Organisms from Hay Infusion: 
Top of the Culture Organism 1: -Relatively big in size, motile with cilia, colorless -Has elongated shape -Doesn't appear to photosynthesize -Size is about 50 micrometers This organisms characteristics are consistent with that of Paramecium Bursaria
Organism 2: -Has a large head with cilia which was attached to a flagella-like body, motile -Colorless -Flower-like shape -Size is 25 micrometers This organisms characteristics are consistent with that of Vorticella
Organism 3: -Small, immobile, and green in color (photosynthesis) -Circular and single-celled with two flagella -Size is about 10 micrometers This organisms characteristics are consistent with that of Chlamydomonas
Bottom of the Culture Organism 1: -Small, motile and colorless -Bean shaped -Uses cilia -Size is about 45 micrometers This organism's characteristics are most similar to that of Colpidium
Organism 2: -Relatively bigger in size, motile with cilia (moves in circles) -Has a yellowish green tint -Rounder in shape -Size is about 75 micrometers This organisms characteristics are consistent with that of Pandorina
Organism 3: -Big, motile with cilia & colorless -Has an elongated shape -Size is about 100 micrometers This organisms characteristics are similar to that of Difflugia
I think one organism that meets all the needs of life is Colpidium because it uses energy to move with it's cilia and it was even observed reproducing under the microscope through binary fission. Also, Colpidium is part of the protozoa group which means it's eukaryotic and has DNA. While having DNA, it also has the ability to evolve over time, especially through mutation.
If the hay infusion had been observed for another two months, I would expect the number of bacteria to increase, remain constant, then decrease over time. Bacteria produce rapidly, so of course over time, the population would increase in number. At one point, however, the hay infusion will reach its carrying capacity and the population number would remain steady. The population would then decrease over time as the water from the hay infusion culture evaporates.
Some selective pressures that may have affected the composition of samples is the availability of oxygen or carbon dioxide and food. Also, the hay infusion, in comparison to the original transect, is much smaller and that would influence the range of species in the culture.
Serial Dilution Procedure (Figure 1): 
Conclusion Results show that organisms do vary between the bottom and the top of the hay infusion culture. This shows how different organisms adapt to different types of environments, even if the discrepancies are minor. This lab procedure seems like a sensible way of achieving the objective and I don't think improvements are necessary.
--Makuo C. Aneke 14:52, 19 February 2014 (EST)MA
Lab 1: 1/30/2014
Objective To understand natural selection and the abiotic and biotic characteristics of a niche. In this lab, we were assigned a transect to collect biotic and abiotic factors.
Procedure 1) Observe samples of green algae and the Volvicine line, determine selective pressures that have taken place, and observe number of cells, colony size, and functional and reproductive specialization. 2) Visit transect, describe characteristics (location, topography, abiotic & biotic factors, etc.), and take soil and vegetation samples. 3) Create a Hay Infusion culture using the samples from the transect.
Data Volvox Number of Cells: about 10 per colony (10x magnification) Colony Size: 45 nanometers Functional Specialization: none Reproductive Specialization: oogamy
Gonium Number of Cells: about 8 per colony (40x magnification) Colony Size: 80 nanometers Functional Specialization: contains chloroplasts Reproductive Specialization: oogamy
Chlamydomonas Number of Cells: about 10 per colony (40x magnification) Colony Size: 40 nanometers Functional Specialization: contains chloroplasts Reproductive Specialization: oogamy
-The significance of cell specialization across these three genera is to see if they can perform photosynthesis with chloroplasts.
-Evolution does not always move toward increased complexity. For example, humans used to have a cecum (like cows) to digest cellulose. Humans have evolved to the point where we don't need to digest vegetation straight from the source, so the cecum (now known as the appendix) can be considered to be a vestigial organ making the human body just a little less complex.
Conclusion Our results show that natural selection will mainly occur due to changes to diet and environment (especially when it comes to more complex organisms).
--Makuo C. Aneke 13:40, 30 January 2014 (EST)Makuo Aneke
You need to ensure that you have answers or information relevant to ALL items in red in the lab handout! 2/18/14 GHH